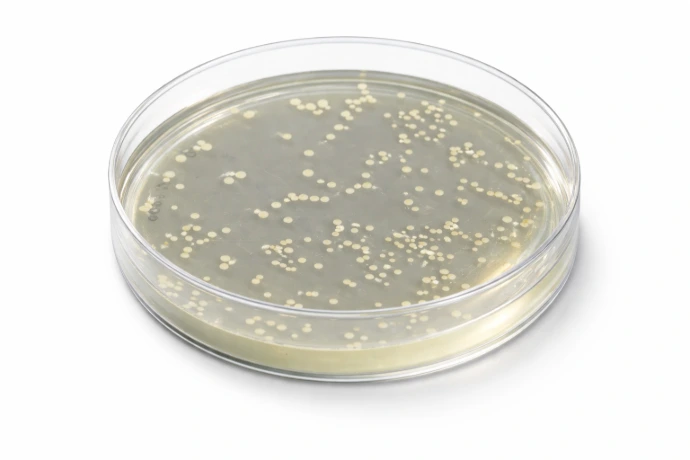

Activities
Lab-grade detection. Field-ready solutions.
We develop custom electrochemical and lateral flow sensing technologies from feasibility to deployment
Applications
Pathogen detection
Custom assays and detection systems for fast and reliable monitoring of pathogens contamination
Water quality monitoring
Custom and integrated sensors for physico-chemical parameters and heavy metals